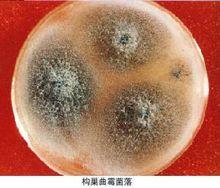
真菌

定義
真菌
真菌 真菌(Fungus)一詞的“拉丁文”Fungus (fungi)原意是蘑菇。
真菌是生物界中很大的一個類群,世界上已被描述的真菌約有 1萬屬12萬餘種(屬與種都是單位,且屬大於種),真菌學家戴芳瀾教授估計中國大約有4萬種(種為單位)。按照林奈(Linneaus)的兩界分類系統,人們通常將真菌門,分為鞭毛菌亞門、接合菌亞門、子囊菌亞門、擔子菌亞門和半知菌亞門。其中,擔子菌亞門是一群多種多樣的高等真菌,多數種具有食用和藥用價值,如銀耳、金針菇、竹蓀、牛肝菌、靈芝等,但也有豹斑毒傘、馬鞍、鬼筆蕈等有毒種。另外,半知菌亞門中約有300屬是農作物和森林病害的病原菌,還有些屬是能引起人類和一些動物皮膚病的病原菌,如稻瘟病菌,可以引起苗瘟、節瘟和谷里瘟等。(fungus;eumycetes)是具有細胞核和細胞壁的異養生物。其營養體除少數低等類型為單細胞外,大多是由纖細管狀菌絲構成的菌絲體。低等真菌的菌絲無隔膜,高等真菌的菌絲都有隔膜,前者稱為無隔菌絲(coenocytic hypha),後者稱有隔菌絲(septate hypha)。在多數真菌的細胞壁中最具特徵性的是含有甲殼質(chitin),其次是纖維素。常見的真菌細胞器有:線粒體,微體,核糖體,液泡,溶酶體,泡囊,內質網,微管,鞭毛等;常見的內含物有肝糖,晶體,脂體等。
在歷史上,真菌曾被認為和植物的關係相近,甚至曾被植物學家認為就是一類植物,但真菌其實是單鞭毛生物,而植物卻是雙鞭毛生物。不同於有胚植物和藻類,真菌不進行光合作用,而是屬於腐生生物——經由腐化並吸收周圍物質來獲取食物。大多數真菌是由被稱為菌絲的微型構造所構成的,這些菌絲或許不被視為細胞,但卻有著真核生物的細胞核。成熟的個體(如最為人熟悉的蕈)是它們的生殖器官。它們和任何可行光合作用的生物都不相關,反而跟動物很親近,兩者同屬後鞭毛生物。因此,真菌被歸類自成一界。
雖然很早就已經知悉真菌和動物的演化關係比植物要來得相近,但很長的一段時間裡,植物學入門對它們的介紹仍然比動物學入門要深入得多。
真菌的形態多樣,一般分為單細胞和多細胞,酵母菌屬於單細胞,而黴菌和蕈菌(大型真菌)都屬於多細胞的真菌,它們歸屬於不同的亞門。大型真菌是指能形成肉質或膠質的子實體或菌核,大多數屬於擔子菌亞門,少數屬於子囊菌亞門。常見的大型真菌有香菇、草菇、金針菇、雙孢蘑菇、平菇、木耳、銀耳、竹蓀、羊肚菌等。它們既是一類重要的菌類蔬菜,又是食品和製藥工業的重要資源。
真菌的細胞既不含葉綠體,也沒有質體,是典型異養生物。它們從動物、植物的活體、死體和它們的排泄物,以及斷枝、落葉和土壤腐殖質中、來吸收和分解其中的有機物,作為自己的營養。真菌的異養方式有寄生和腐生。
真菌常為絲狀和多細胞的有機體,其營養體除大型菌外,分化很小。高等大型菌有定型的子實體。除少數例外,真菌都有明顯的細胞壁,通常不能運動,以孢子的方式進行繁殖。
常見的真菌感染多為白色念珠菌、陰道纖毛菌、放線菌等。鹽水塗片中注意尋找真菌孢子、菌絲或纖毛菌叢。
兩大結構
營養體
 真菌
真菌 真菌營養生長階段的結構稱為營養體。絕大多數真菌的營養體都是可分枝的絲狀體,單根絲狀體稱為菌絲(hypha)。許多菌絲在一起統稱菌絲體(mycelium)。菌絲體在基質上生長的形態稱為菌落(colony)。菌絲在顯微鏡下觀察時呈管狀,具有細胞壁和細胞質,無色或有色。菌絲可無限生長,但直徑是有限的,一般為2—30微米,最大的可達100微米。低等真菌的菌絲沒有隔膜(septum)稱為無隔菌絲,而高等真菌的菌絲有許多隔膜,稱為有隔菌絲。此外,少數真菌的營養體不是絲狀體。而是無細胞壁且形狀可變的原質團(plasmodium)或具細胞壁的、卵圓形的單細胞。寄生在植物上的真菌往往以菌絲體在寄主的細胞間或穿過細胞擴展蔓延。
當菌絲體與寄主細胞壁或原生質接觸後,營養物質因滲透壓的關係進入菌絲體內。有些真菌如活體營養生物侵入寄主後,菌絲體在寄主細胞內形成吸收養分的特殊機構稱為吸器(hauStorium)。吸器的形狀不一,因種類不同而異,如白粉菌吸器為掌狀,霜黴菌為絲狀,鏽菌為指狀,白鏽菌為小球狀。有些真菌的菌絲體生長到一定階段,可形成疏鬆或緊密的組織體。菌絲組織體主要有菌核(sclerotium)、子座(stroma)和菌索(rhizomorph)等。菌核是由菌絲緊密交織而成的休眠體,內層是疏絲組織,外層是擬薄壁組織,表皮細胞壁厚、色深、較堅硬。菌核的功能主要是抵抗不良環境。但當條件適宜時,菌核能萌發產生新的營養菌絲或從上面形成新的繁殖體。菌核的形狀和大小差異較大,通常似綠豆、鼠糞或不規則狀。子座是由菌絲在寄主表面或表皮下交織形成的一種墊狀結構,有時與寄主組織結合而成。子座的主要功能是形成產生孢子的機構,但也有度過不良環境的作用。菌索是由菌絲體平行組成的長條形繩索狀結構,外形與植物的根有些相似,所以也稱根狀菌索。菌索可抵抗不良環境,也有助於菌體在基質上蔓延。
有些真菌菌絲或孢子中的某些細胞膨大變圓、原生質濃縮、細胞壁加厚而形成厚垣孢子(chlamydospore)。它能抵抗不良環境,待條件適宜時,再萌發成菌絲。
當很多菌絲聚集在一起時,會組成真菌的營養體,即 菌絲體。菌絲一般分為兩類,一為無隔菌絲,即菌絲沒有橫隔壁,可視為一個單細胞,具有多個細胞核,如低等真菌中的根霉、毛霉、水霉等的菌絲。另一類是有隔菌絲,即菌絲具很多橫隔壁,將其分隔成多個細胞,每個細胞中有1個、2個或多個細胞核。
繁殖體
當營養生活進行到一定時期時,真菌就開始轉入繁殖階段,形成各種繁殖體即子實體(fruitingbody)。真菌的繁殖體包括無性繁殖(asexual reproduction)形成的無性孢子和有性生殖(sexual reproduction)產生的有性孢子。
繁殖方式
無性繁殖
無性繁殖(asexual reproduction)是指營養體不經過核配和減數分裂產生後代個體的繁殖。它的基本特徵是營養繁殖通常直接由菌絲分化產生無性孢子。常見的無性孢子有三種類型:
 真菌
真菌 ⑴遊動孢子(zoospore):形成於遊動孢子囊(zoosporangium)內。遊動孢子囊由菌絲或孢囊梗頂端膨大而成。遊動孢子無細胞壁,具1—2根鞭毛,釋放後能在水中遊動。
⑵孢囊孢子(sporangiospore):形成於孢囊孢子囊(sporangium)內。孢子囊由孢囊梗的頂端膨大而成。孢囊孢子有細胞壁,水生型有鞭毛,釋放後可隨風飛散。
⑶分生孢子(conidium)產生於由菌絲分化而形成的分生孢子梗(conidiophore)上,頂生、側生或串生,形狀、大小多種多樣,單胞或多胞,無色或有色,成熟後從孢子梗上脫落。有些真菌的分生孢子和分生孢子梗還著生在分生孢子果內。孢子果主要有兩種類型,即近球形的具孔口的分生孢子器(pycnidium)和杯狀或盤狀的分生孢子盤(acervulus)。
有性生殖
真菌的有性生殖
真菌並沒有整條的性染色體 ,只有一些DNA片段起著相同的作用。這種DNA片段被稱為“交配型位點”(MAT)或“性別位點”(sex loci)。依照這一點,將真菌的性別分為正、負兩種。無論正負性別,它們都有同一個基因來解碼HMG蛋白的位點蛋白。HMG蛋白(high-mobility group protein)也即高遷移率蛋白,它可以通過一種未知途徑來調控性別差異。這種基因和Y染色體上發現的主要調控基因“sry”蛋白極其類似
真菌生長發育到一定時期(一般到後期)就進行有性生殖(sexual reproduction)。有性生殖是經過兩個性細胞結合後細胞核產生減數分裂產生孢子的繁殖方式。多數真菌由菌絲分化產生性器官即配子囊(gametangium),通過雌、雄配子囊結合形成有性孢子。其整個過程可分為質配(plasmogamy)、核配(karyogamy)和減數分裂(meiosis)三個階段。
第一階段是質配,即經過兩個性細胞的融合,兩者的細胞質和細胞核(N)合併在同一細胞中,形成雙核期(N+N)。
第二階段是核配,就是在融合的細胞內兩個單倍體(haploid)的細胞核結合成一個雙倍體的核(2N)。
第三階段是減數分裂,雙倍體(diploid)細胞核經過兩次連續的分裂,形成四個單倍體的核(N),從而回到原來的單倍體階段。經過有性生殖,真菌可產生四種類型的有性孢子。
⑴卵孢子(oospore):卵菌的有性孢子。是由兩個異型配子囊——雄器和藏卵器接觸後,雄器的細胞質和細胞核經授精管進入藏卵器,與卵球核配,最後受精的卵球發育成厚壁的、雙倍體的卵孢子。
⑵接合孢子(zygospore):接合菌的有性孢子。是由兩個配子囊以配子囊結合的方式融合成1個細胞,並在這個細胞中進行質配和核配後形成的厚壁孢子。
⑶子囊孢子(ascospore):子囊菌的有性孢子。通常是由兩個異型配子囊——雄器和產囊體相結合,經質配、核配和減數分裂而形成的單倍體孢子。子囊孢子著生在無色透明、棒狀或卵圓形的囊狀結構即子囊(ascus)內。每個子囊中一般形成8個子囊孢子。子囊通常產生在具包被的子囊果內。子囊果一般有四種類型,即球狀而無孔口的閉囊殼(cletothecium),瓶狀或球狀且有真正殼壁和固定孔口的子囊殼(perithecium),由於座溶解而成的、無真正殼壁和固定孔口的子囊腔(locule),以及盤狀或杯狀的子囊盤(9pothecium)。
⑷擔孢子(basidiospore):擔子菌的有性孢子。通常是直接由“+”、“-”菌絲結合形成雙核菌絲,以後雙核菌絲的頂端細胞膨大成棒狀的擔子(basidium)。在擔子內的雙核經過核配和減數分裂,最後在擔子上產生4個外生的單倍體的擔孢子。
此外,有些低等真菌如根腫菌和壺菌產生的有性孢子是一種由遊動配子結合成合子,再由合子發育而成的厚壁的休眠孢子(restingspore)。
起源和演化
真菌的起源、演化和系統發育的研究,最初是根據比較形態學和細胞學的資料。20世紀80年代後,隨著科學技術的發展和新技術的廣泛套用,例如G—C含量、胞壁的多糖組分和結構的研究、各類真菌色氨酸生物合成途徑的酶沉降圖型、賴氨酸的兩種不同合成途徑以及rRNA序列的研究等,都推動了真菌起源和演化的研究。
起源
真菌在地球上存在了多長時間還不清楚,對真菌的起源也沒有確切的結論。真菌的有些特點和植物相似,然而在某些方面又和動物有相似之處。二十世紀80~90年代,根據營養方式的比較研究,真菌不是植物也不是動物,而是一個獨立的生物類群——真菌界。
①起源多元論:根據性器官的形態及交配方式,認為真菌來自藻類。壺菌目自原藻演化而來;水霉目演自無隔藻;毛霉演自接合藻;子囊菌和擔子菌由紅藻演化而來,這些藻類因喪失色素而從自養變成異養,生理的變化引起了形態的改變。這就是真菌起源的多元論觀點。
②鞭毛生物起源論:認為絕大多數真菌是起源於一種原始水生生物——鞭毛生物,單細胞,具一至數根鞭毛,有的有葉綠素和其他色素,有的無色素,具色素的演化為藻類,無色素的演化為菌類。真菌和藻類都起源於鞭毛生物。
演化
①生活方式上:水生真菌是原始型,演化的過程是由水生到陸生,並且推測在演化過程中還可能返回水生的習性。從而認為具有鞭毛的遊動孢子較原始,而不遊動的靜止孢子是相對進化的。
②營養方式上:腐生方式是原始的生活類型,寄生生活方式比腐生生活方式高級。專性寄生生活方式比兼性寄生生活方式高級,最高級的生活方式是特異性的專性寄生方式。
③真菌結構上:由簡單到複雜,再由複雜退化和失去特殊的結構,使結構簡單化。
新技術的廣泛套用,對修訂真菌的起源和演化提供了科學依據。擔子菌。
系統分類
壺菌門
壺菌門(Chytridiomycota)壺菌門是遊動細胞具有“9+2”結構的鞭毛,並能在水中遊動的一類真菌,遊動孢子具有一根後生尾鞭式鞭毛。
接合菌門
接合菌門(Zygomycota)是由低等的水生真菌發展到陸生種類,由遊動的帶鞭毛的孢囊孢子發展為不遊動的孢囊孢子——靜孢子或單孢孢子囊的分生孢子。
子囊菌門
子囊菌門(Ascomycota)是真菌中最大的類群他與擔子菌被稱為高等真菌,生殖菌絲細胞出現較短雙核階段,其區別於其他真菌的一個特徵是產生子囊。
擔子菌門
擔子菌門(Basidiomycota)是一類高等真菌,構成雙核亞界,包含2萬多種,包括蘑菇、木耳等主要食用菌。更具體地說,擔子菌門包括以下組:蘑菇,馬勃,stinkhorns(鬼筆科),支架真菌,和人體致病酵母隱球菌屬等等。
半知菌類
半知菌類(Deuteromycota)是一種已廢止的生物分類,指在子囊菌・擔子菌的同伴之中,還未發現有性繁殖階段而在分類學上位置不明的一種臨時分類。只進行無性繁殖的菌類被稱作不完全型,這一階段被稱為無性階段。進行有性繁殖的被稱為完全型,該階段被稱作有性階段,通常有性階段的菌類也是同時進行無性生殖的。
相關概念
假菌絲
某些酵母如假絲酵母經出芽繁殖後,子細胞結成長鏈,並有分枝,稱為假菌絲。細胞間連線處較為狹窄,如藕節狀,一般沒有隔膜。
抗菌素
亦稱“抗生素”。主要指微生物所產生的能抑制或殺死其他微生物的化學物質,如青黴素、金黴素、春雷黴素、慶大黴素等。從某些高等植物和動物組織中也可提得抗菌素。有些抗菌素,如氯黴素和環絲氨酸,化學結構,可以獲得性能較好的新抗菌素,如半合成的新型青黴素。在醫學上,廣泛地套用抗菌素以治療許多微生物感染性疾病和某些癌症等。在畜牧獸醫學方面,不僅用來防治某些傳染病,有些抗菌素還可用以促進家禽、家畜的生長。在農林業方面,可用以防治植物的微生物性病害。在食品工業上,則可用作某些食品的保存劑。
各類真菌特徵
公元前1550年,古埃及有醫生用豬油調蜂蜜來敷貼,然後用麻布包紮因外傷感染而發炎紅腫的疾病。但當時並不知道這么做的醫學意義在於抑菌。1867年,英格蘭外科醫生李斯特首創石炭酸(化學名為“苯酚”)消毒法,使手術後感染的死亡率由60%下降到了15%。但是濫用抗生素會對人體不利。
發現
1877年,Pasteur和Joubert首先認識到微生物產品有可能成為治療藥物,他們發表了實驗觀察,即普通的微生物能抑制尿中炭疽桿菌的生長。
1910年,德國醫生埃爾利希在第606個配方實驗中取得了成功,就是現在還在用的阿斯凡納明,代號“埃爾利希606”。
1922年,微生物學家亞歷山大·弗萊明從人體鼻腔分泌物中觀察到一種酶,即“溶菌酶”,具有抵抗微生物的能力[1]。
1928年,亞歷山大·弗萊明又發現一種抗生現象,那就是青黴素的抗生作用。1929年,發表了題為《論青黴菌培養物的抗菌作用》的論文,這一年被視為“抗生素元年”。但青黴素極不穩定,提純很困難。
1932年,德國化學工業巨頭克拉爾合成了一種鮮艷的橙色染料。同年,細菌學家兼藥物學家多馬克嘗試著用這種染料來殺滅鏈球菌,首先在老鼠身上實驗成功。它的問世,標誌著抗生素時代的開始。
淘菌時代
金黴素(1947年)、氯黴素(1948年)、土黴素(1950年)、制黴菌素(1950年)、紅黴素(1952年)、卡那黴素(1958年)等都是在這期間發現的。這一時期,抗生素研究也進入了有目的、有計畫、系統化的階段,還建立了大規模的抗菌素製藥工業。
1936年,磺胺的臨床套用開創了現代抗微生物化療的新紀元。
1941年,猶太裔德國人錢恩與來自澳大利亞、在牛津大學做訪問學者的弗洛里合作,成功分離出了青黴素。
1944年,青黴素首次在美國生產出來。人們把青黴素同核子彈、雷達並列為第二次世界大戰中的三大發明。
1944年,新澤西大學分離出來第二種抗生素鏈黴素,有效治癒了另一種傳染病:結核。
1947年,出現氯黴素,它主要針對痢疾、炭疽病菌,治療輕度感染。
1948年,出現最早的廣譜抗生素——四環素。在當時看來,它能夠在還未確診的情況下有效地使用。
1956年,禮來公司發明了萬古黴素,被稱為抗生素的最後武器。
發展放緩
1958年,希恩合成了6-氨基青黴烷酸,開闢了生產半合成青黴素的道路。
進入20世紀60年代後,人們從自然界中尋找新的抗生素的速度明顯放慢,取而代之的是半合成抗生素的出現。
黃金時期
20世紀50年代至70年代,是抗生素開發的黃金時期,新上市的抗生素逐年增多。1971年至1975年達到頂峰,5年間共有52種新抗生素問世。
再次放緩
20世紀80年代開始,每年新上市的抗生素逐年遞減。1996年至2000年的5年中,只開發出6種新抗生素。
1980年,代喹諾酮類藥物出現。和其他抗菌藥不同,它們破壞細菌染色體,不受基因交換耐藥性的影響。
1990年,Monaghan等將這類微生物產生的活性物質,命名為生物藥物素。
2003年全球僅一個新產品——達托黴素上市。
作用機理
1、阻礙細菌細胞壁的合成,導致細菌在低滲透壓環境下膨脹破裂死亡。哺乳動物的細胞沒有細胞壁,不受這類藥物的影響。喹諾酮類抗生素三大不良反
2、與細菌細胞膜相互作用,增強細菌細胞膜的通透性、打開膜上的離子通道,讓細菌內部的有用物質漏出菌體或電解質平衡失調而死。
3、與細菌核糖體或其反應底物(如tRNA、mRNA)相互所用,抑制蛋白質的合成——這意味著細胞存活所必需的結構蛋白和酶不能被合成。
4、阻礙細菌DNA的複製和轉錄,阻礙DNA複製將導致細菌細胞分裂繁殖受阻,阻礙DNA轉錄成mRNA則導致後續的mRNA翻譯合成蛋白的過程受阻。
基本分類
糖的衍生物
主要由氨基己糖的衍生物組成。
多肽類抗生素
主要或全部由胺基酸組成,有多肽或蛋白質的某些特性。
多烯類抗生素
分子結構中有多個雙鍵。
大環內酯抗生素
由一個或多個單糖組成並與碳鏈一起形成一個巨大的芳香內酯化合物。
四環類抗生素
都具有四個縮合苯環。
嘌呤類抗生素
都含有嘌呤環。
基本特點
直接作用於菌體細胞
抗生素則能選擇性地作用於菌體細胞DNA、 RNA和蛋白質合成系統的特定環節,干擾細胞的代謝作用,妨礙生命活動或使停止生長,甚至死亡。而不同於無選擇性的普通消毒劑或殺菌劑。
具有選擇性
抗生素的作用具有選擇性,不同抗生素對不同病原菌的作用不一樣。對某種抗生素敏感的病原菌種類稱為該抗生素的抗生譜(抗菌譜)。
有效作用濃度
抗生素是一種生理活性物質。各種抗生素一般都在很低濃度下對病原菌就發生作用,這是抗生素區別於其他化學殺菌劑的又一主要特點。各種抗生素對不同微生物的有效濃度各異,通常以抑制微生物生長的最低濃度作為抗生素的抗菌強度,簡稱有效濃度。有效濃度越低,表明抗菌作用越強。
不良反應
1、神經系統毒性反應;寶寶最怕的5種抗生素
2、造血系統毒性反應;
3、肝、腎毒性反應;
4、胃腸道反應;
5、抗生素可致菌群失調,引起維生素B族和K缺乏;
6、抗生素的過敏反應一般分為過敏性休克、血清病型反應、藥熱、皮疹、血管神經性水腫和變態反應性心肌損害等。
7、抗生素後遺效應是指停藥後的後遺生物效應。
基本用途
1、抗生素最主要用於醫療方面。抗生素_圖片_互動百科
2、對抗在人或動物體內的致病菌等病原體,可治療大多數細菌、立克次體、支原體、衣原體、螺旋體等微生物感染導致的疾病。
3、對於病毒、朊毒體等結構簡單的病原體所引起的疾病沒有效用。
4、除了抗細菌性的感染外,某些抗生素還具有抗腫瘤活性,用於腫瘤的化學治療。
5、有些抗生素還具有免疫抑制作用。
6、抗生素除用於醫療,還套用於生物科學研究、農業、畜牧業和食品工業等方面。
7、在畜牧業和農業中非治療用途的抗生素,稱為抗生素生長促進劑。
黴菌
亦稱“絲狀菌”。屬真菌。體呈絲狀,叢生,可產生多種形式的孢子。多腐生。種類很多,常見的有根霉、毛霉、麴黴和青黴等。黴菌可用以生產工業原料(檸檬酸、甲烯琥珀酸等),進行食品加工(釀造醬油等),製造抗菌素(如青黴素、灰黃黴素)和生產農藥(如“920”、白僵菌)等。但也能引起工業原料和產品以及農林產品發霉變質。另有一小部分黴菌可引起人與動植物的病害,如頭癬、腳癬及番薯腐爛病等。
酵母菌
酵母菌的生殖方式分無性繁殖和有性繁殖兩大類。
無性繁殖包括:芽殖,裂殖,芽裂。
有性繁殖方式:子囊孢子。
屬真菌。體呈圓形、卵形或橢圓形,內有細胞核、液泡和顆粒體物質。通常以出芽繁殖;有的能進行二等分分裂;有的種類能產生子囊孢子。廣泛分布於自然界,尤其在葡萄及其他各種果品和蔬菜上更多。是重要的發酵素,能分解碳水化合物產生酒精和二氧化碳等。生產上常用的有麵包酵母、飼料酵母、酒精酵母和葡萄酒酵母等。有些能合成纖維素供醫藥使用,也有用於石油發酵的。
啤酒酵母(Saccharomyces)屬酵母菌屬。細胞呈圓形、卵形或橢圓形。以出芽繁殖,能形成子囊孢子。在發酵工業上,可用來發酵生產酒精或藥用酵母,也可通過菌體的綜合利用提取凝血質、麥角固醇、卵磷脂、輔酶甲與細胞色素丙等產品。
紅麴黴素(Monascuspurpureus)屬於囊菌綱,麴黴科。菌絲體紫紅色。無性生殖時,茵絲分枝頂端形成單獨的或一小串球形或梨形的分生抱子。有性生殖時,產生球形、橙紅色的閉囊果,內生含有八個子囊孢子的子囊。紅麴黴可制紅曲、釀製紅乳腐和生產糖化酶等。
假絲酵母(Candida)
 白色念珠菌
白色念珠菌 一屬能形成假菌絲、不產生子囊孢子的酵母。不少的假絲酵母能利用正烷烴為碳源進行石油發酵脫蠟,並產生有價值的產品。其中氧化正烷烴能力較強的假絲酵母多是解脂假絲酵母(C.lipolytica)或熱帶假絲酵母(C.tropicalis)。有些種類可用作飼料酵母;個別種類能引起人或動物的疾病。
白色念珠菌(Candidaalbicans)
或亦稱“白色假絲酵母”。一種呈橢圓形、行出芽繁殖的假絲酵母。通常存在於正常人的口腔、腸道、上呼吸道等處,能引起鵝口瘡等口腔疾病或其他疾病。
黃麴黴(Aspergillusflavus)
半知菌類,黃麴黴群的一種常見腐生真菌。多見於發霉的糧食、糧食製品或其他霉腐的有機物上。菌落生長較快,結構疏鬆,表面黃綠色,背面無色或略呈褐色。菌體由許多複雜的分枝菌絲構成。營養菌絲具有分隔;氣生菌絲的一部分形成長而粗糙的分生孢子梗,梗的頂端產生燒瓶形或近球形的頂囊,囊的表面產生許多小梗(一般為雙層),小梗上著生成串的表面粗糙的球形分生孢子。分生孢子梗、頂囊、小梗和分生孢於合成孢子穗。可用於生產澱粉酶、蛋白酶和磷酸二酯酶等,也是釀造工業中的常見菌種。黃麴黴毒素。早在六世紀時,《齊民要術》中就有用“黃衣”、“黃蒸”兩種麥曲來制醬的記載,這兩種黃色的麥曲,主要由黃麴黴一類微生物產生的大量孢子和蛋白酶、澱粉酶所組成。
白地霉(Geotrichumcandidum)
屬真菌。菌落平面擴散,組織輕軟,乳白色。菌絲生長到一定階段時,斷裂成圓柱狀的裂生抱子。菌體生長最適宜的溫度為28℃。常見於牛奶和各種乳製品(如酸牛奶和乳酪)中;在泡菜和醬上,也常有白地霉。可用來製造核苦酸、酵母片等。
抗生菌
亦稱“拮(頡)抗菌”。能抑制別種微生物的生長發育,甚至殺死別種微生物的一些微生物。其中有的能產生抗菌素,主要是放線菌及若干真菌和細菌等。如鏈黴菌產生鏈黴素,青黴菌產生青黴素,多粘芽抱桿菌產生多粘菌素等。
毒性及病原性
對人類致病的真菌分淺部真菌和深部真菌,前者侵犯皮膚、毛髮、指甲,為慢性,對治療有頑固性,但影響身體較小,後者可侵犯全身內臟,嚴重的可引起死亡。此外有些真菌寄生於糧食、飼料、食品中,能產生毒素引起中毒性真菌病。
培養
 真菌
真菌 常見真菌培養基有:
配方一 薩市(Sabouraud’s)培養基
蛋白腖10克瓊脂20克
麥芽糖40克 水 1000毫升
先把蛋白腖、瓊脂加水後,加熱,不斷攪拌,待瓊脂溶解後,加入40克麥芽糖(或葡萄糖),攪拌,使它溶解,然後分裝,滅菌,備用。
本培養菌是培養許多種類真菌所常用的。
配方二 馬鈴薯糖瓊脂培養基
把馬鈴薯洗淨去皮,取200克切成小塊,加水1000毫升,煮沸半小時後,補足水分。在濾液中加入10克瓊脂,煮沸溶解後加糖20克(用於培養黴菌的加入蔗糖,用於培養酵母菌的加入葡萄糖),補足水分,分裝,滅菌,備用。
把這培養基的pH值調到7.2~7.4,配方中的糖,如用葡萄糖還可用來培養放線菌和芽孢桿菌。
配方三 黃豆芽汁培養基
黃豆芽 100克 瓊脂 15克
葡萄糖20克 水 1000毫升
洗淨黃豆芽,加水煮沸30分鐘。用紗布過濾,濾液中加入瓊脂,加熱溶解後放入糖,攪拌使它溶解,補足水分到1000毫升,分裝,滅菌,備用。
把這培養基的pH值調到7.2~7.4,可用來培養細菌和放線菌。
配方四 豌豆瓊脂培養基
豌豆 80粒 瓊脂 5克
水 200毫升
取80粒乾豌豆加水,煮沸1小時,用紗布過濾後,在濾液中加入瓊脂,煮沸到溶解,分裝,滅菌,備用。
真菌的菌落特徵
在自然基質或人工培養基上由一段 ( 或一叢) 菌絲或一個 ( 或一堆 ) 孢子發展而成的菌絲體的整體稱菌落。黴菌的菌落和放線菌一樣也是由分枝狀菌絲組成。因菌絲較粗而長,形成的菌落較疏鬆,呈絨毛狀、絮狀或蜘蛛網狀,一般比細菌菌落大幾倍到幾十倍。有些黴菌,如根霉、毛霉、鏈孢霉生長很快,菌絲在固體培養基表面蔓延,以至菌落沒有固定大小 。有的黴菌菌落生長則有一定的局限性,直徑1-2cm 或更小。菌落表面常呈現出肉眼可見的不同結構和色澤特徵,這是因為黴菌形成的孢子有不同形狀、構造和顏色,有的水溶性色素可分泌到培養基中,使菌落背面呈現不同顏色;一般處於菌落中心的菌絲菌齡較大,位於邊緣的則較年幼。菌落具有“霉味”。同一種黴菌,在不同成分培養基上的菌落特徵可能有變化。但各種黴菌,在同一培養基上的菌落形狀、顏色等相對穩定。故菌落特徵也是鑑定黴菌的重要依據之一。
酵母菌的菌落與細菌的有些相似,但較細菌菌落大而厚,一般呈油脂或蠟脂狀,表面光滑、濕潤、呈乳白色或紅色。有些種的菌落可因培養時間過長而表面皺縮。酵母菌菌落往往有“酒香味”。
真菌與生活
環境的再循環
真菌像細菌和微生物一樣都是分解者,就是一些分解死亡生物的有機物的生物。真菌將生物分解為各類無機物,使土地肥力增強。
食物與真菌
還有些真菌也成為重要的食物來源。可食用的蕈菌有200多種,如冬菇、草菇、木耳、雲耳等。以及真菌所侵入後的生(動,植物)物空殼,如冬蟲夏草。
還有的真菌用於食物加工,例如酵母菌用於麵包等加工,釀酒也需要真菌。
致病的真菌
在農業、林業和畜牧業中,真菌又有有害的一面。真菌能引起植物多種病害,從而造成巨大的經濟損失。例如,1845年歐洲由於馬鈴薯晚疫病的流行摧毀了5/6的馬鈴薯,中國由於1950年的小麥鏽病和1974年的稻瘟病而使小麥和水稻各減產60億千克。
真菌還可引起動、植物和人類的多種疾病,在人類主要有三種類型:①.真菌感染; ②.變態反應性疾病;③.中毒性疾病。
需抗真菌藥
抗病的真菌
亞歷山大·弗萊明由於一次幸運的過失而發現了青黴素。有一次他外出度假時,把實驗室里在培養皿中正生長著細菌這件事給忘了。3周后當他回實驗室時,注意到在一個培養皿中長了一個黴菌斑。並且黴菌斑周圍的細菌都死了。
黴菌滲出了什麼強有力的物質?弗萊明稱為青黴素,並發現了它可以殺死許多致命性細菌。然而,因為青黴素在試管內和血清混合後很快失活,弗萊明認為它不會在人和動物身上發生作用。
共生關係
植物的根和真菌也有共生關係,和真菌共生的根稱為菌根。
外生菌根(Ectomycorrhizae):真菌的菌絲在根的表面形成菌絲體包在幼根的表面,有時也侵入皮層細胞間,但不進入細胞內,此時以菌絲代替了根毛的功能,增加了根系的吸收面積,如松等;
內生菌根(endomycorrhizae):菌絲通過細胞壁侵入到表皮和皮層細胞內,加強吸收機能,促進根內的物質運輸,如柑橘、核桃等;
內外生菌根:也有菌絲不僅包在幼根表面同時也深入到細胞中,稱內外生菌根,如蘋果、柳樹等。
菌絲吸收水分、無機鹽等供給植物,同時產生植物激素和維生素B等促進根系的生長;植物供給真菌糖類、胺基酸等有機養料。
能形成菌根的高等植物2000多種,如側柏、毛白楊、銀杏、小麥、蔥等;
具菌根的植物在沒有真菌存在時不能正常生長,因此造林時須事先接種和感染所需真菌,以利於荒地上成功造林。
研究史
外國分類
1、在林奈(1735)建立的兩界分類系統(動物界和植物界)中,真菌屬於植物界。
2、在Hogg(1860)和 Haeckel(1866)先後建立的三界分類系統(原生生物界、動物界和植物界)中,真菌屬於原生生物界。
3、在Copeland(1938)建立的四界分類系統(菌界、原生生物界、動物界和植物界)中,真菌屬於原生生物界。
4、在Wittaker(1969)建立的五界分類系統(原核生物界、原生生物界、植物界、真菌界和動物界)中,把真菌單獨作為一界處理。這是一個比較完整的縱橫統一的系統,在縱的方面顯示了生物進化的三大階段,即無細胞生物→原核單胞生物→真核(單胞→多胞)生物。在橫的方面顯示了生物演化的三大方向,即光合作用的植物,吸收營養的真菌和攝食的動物。
中國分類
1、胡先驌(1965)把生物分為二個總界分類系統(始生總界和胞生總界),其中,始生總界包括病毒,胞生總界包括(細菌界、粘菌界、植物界、真菌界和動物界)。
2、陳世驤等(1979)建議的五界分類系統,根據生命進化歷史的主要階段,即無細胞階段→原核階段→真核階段而分的。無細胞階段包括病毒;原核階段包括細菌和藍藻,形成一個菌藻生態系統;真核階段是由植物、真菌和動物形成的生態系統。三個階段成為三個總界,總界下設六個界:即病毒界、細菌界、藍藻界、植物界、真菌界、動物界。
⑴非細胞總界(無細胞階段)
①病毒界
⑵原核總界(原核階段)
②細菌界
③藍藻界
⑶真核總界(真核階段)
④植物界
⑤真菌界
⑥動物界
與細菌區別
植物和動物都是由細胞組成的,細胞內都有細胞核,而微生物中只有真菌具有真正的細胞核和完整的細胞器,故又稱真核細胞型微生物;細菌僅有原始核結構,無核膜和核仁,細胞器很少,屬於原核細胞型微生物;而病毒則沒有細胞結構,屬於原生微生物。所以,雖然有些真菌也很微小,也能使人生病,但它與細菌和病毒有著本質的區別。
微生物學辭彙
| 微生物學(microbiology)生物學的分支學科之一。它是在分子、細胞或群體水平上研究各類微小生物(細菌、放線菌、真菌、病毒、立克次氏體、支原體、衣原體、螺旋體原生動物以及單細胞藻類)的形態結構、生長繁殖、生理代謝、遺傳變異、生態分布和分類進化等生命活動的基本規律,並將其套用於工業發酵、醫學衛生和生物工程等領域的科學。 |

